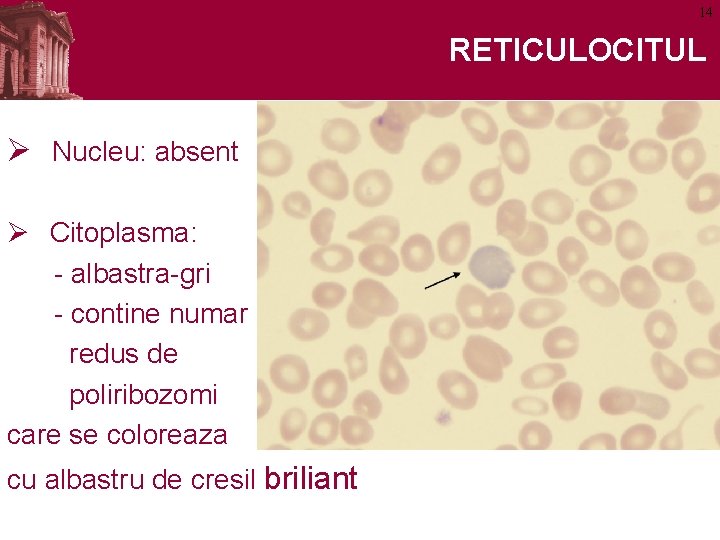
14 RETICULOCITUL Ø Nucleu: absent Ø Citoplasma: - albastra-gri - contine numar redus de

HEMATOPOIEZA ELEMENTELE FIGURATE ALE MDUVEI HEMATOPOIETICE 2 HEMATOPOIEZA

- Slides: 36
HEMATOPOIEZA ELEMENTELE FIGURATE ALE MĂDUVEI HEMATOPOIETICE
2 HEMATOPOIEZA Ø Reprezintă procesul de formare a elementelor figurate sanguine Ø Cuprinde: eritropoieza, mielopoieza, limfopoieza, monocitopoieza şi trombopoieza
3 HEMATOPOIEZA Nu pot fi Ø Celula stem pluripotentă distinse Ø Celule progenitoare (CFU, CFC*) morfologic Ø Celule precursoare (blaşti) *CFU/CFC = Unități/Celule formatoare de colonii
4 MĂDUVA HEMATOGENĂ Diagnostic histologic pozitiv: – Alcătuită din stromă (țesut conjunctiv reticular) ce conține cordoanele hematopoietice şi capilare sinusoide. – Prezenţa megacariocitului trombocitogen
5 MADUVA OSOASA HEMATOGENA Ø Două tipuri de preparate microscopice: – Secţiuni: toate componentele sunt prezente (stroma + vase sangvine + adipocite + cordoane (insule ) hematopoietice) – Puncţie medulară -> frotiu: numai celulele hematopoietice şi elemente adulte ale sângelui periferic
6 SECTIUNE PRIN MADUVA OSOASA
7 FROTIU MADUVA OSOASA HEMATOGENA
8
9 SERIA ROSIE (ERITROPOIEZA) Ø Formată din : • proeritroblast, • eritroblast bazofil, • eritroblast policromatofil, • eritroblast acidofil, • reticulocit, • eritrocit Ø Regulă generală : 1. Toţi blaştii au nucleu 2. Nici o celulă din seria roşie nu are granulaţii în citoplasmă
10 PROERITROBLASTUL 20 -25 mm Ø Nucleu: - veziculos - cu nucleoli Ø Citoplasma: - intens bazofilă - cu halou clar perinuclear
11 ERITROBLASTUL BAZOFIL 16 -18 mm Ø Nucleu: - excentric - sferic - cu heterocromatina dispusă în gramezi radiare, Ø Citoplasma: - bazofilă (cea mai bazofilă celulă) -haloul perinuclear şters
12 ERITROBLASTUL POLICROMATOFIL 9 -12 mm Ø Nucleu: - excentric, - heterocromatic, Ø Citoplasma: - colorata în albastru palid şi roz, -amfofilă datorită apariţiei hemoglobinei
13 ERITROBLASTUL ACIDOFIL/OXIFIL 8 -9 mm Ø Nucleu: - picnotic, - excentric Ø Citoplasmă: acidofilă
14 RETICULOCITUL Ø Nucleu: absent Ø Citoplasma: - albastra-gri - contine numar redus de poliribozomi care se coloreaza cu albastru de cresil briliant
15
16 SERIA GRANULOCITARĂ Ø Formată din : • mieloblast, • promielocit • metamielocit • granulocit nesegmentat • granulocit segmentat Neutrofil, eozinofil sau bazofil Ø Regulă generală : 1. “Blaştii” au nucleu eucromatic cu nucleol 2. “Citele” au nucleu heterocromatic
17 MIELOBLASTUL 15 -20 mm Ø Nucleu: veziculos cu 1 -4 nucleoli, Ø Citoplasmă: - abundentă, - bazofilă, - fără granulaţii, - cu discret halou perinuclear
18 PROMIELOCITUL 20 -25 mm Ø Nucleu: - uşor excentric, - cu nucleoli, Ø Citoplasmă: - abundentă, - bazofilă, - cu granulaţii azurofile: - inegale, - variabile ca număr şi dispoziţie
19 MIELOCITUL NEUTROFIL 15 -20 mm Ø Nucleu: - heterocromatina în retea mai densă, Ø Citoplasma: - granulaţii specifice: - numeroase, - violet închis, - inegale - bazofilă sau amfofilă,
20 MIELOCITUL EOZINOFIL 20 -25 mm Ø Nucleu: - heterocromatina în retea mai densă, Ø Citoplasma: - granulaţii specifice numeroase, sferice, acidofile - bazofilă sau amfofilă
21 MIELOCITUL BAZOFIL 13 -15 mm Ø Nucleu: - heterocromatina în retea mai densă, Ø Citoplasmă: - granulaţii specifice: - numeroase, - inegale, - bazofile, acoperă şi nucleul - slab bazofilă,
22 METAMIELOCITUL Ø Nucleul: devine reniform, Ø Granulațiile și citoplasma: îşi păstrează aspectul la toate cele 3 serii
23 GRANULOCITUL NEUTROFIL NESEGMENTAT Ø Nucleul: are aspect de corn, U sau S, Ø Granulații specifice Ø Citoplasma: acidofilă
24 SERIA MEGACARIOCITARĂ Ø Formată din: • Megacarioblastul – 15 - 50µm nucleu reniform, cu nucleoli, citoplasma bazofilă cu granulaţii azurofile • Megacariocitul tânăr – 80µm nucleu lobulat, fără nucleoli, citoplasma cu afinităţi tinctoriale diferite, acidofilă sau bazofilă • Megacariocitul trombocitogen - 150µm formă neregulată, este cea mai mare celulă a măduvei hematogene, nucleul este înmugurit, citoplasma acidofilă, granulaţii azurofile
25 SERIA MEGACARIOCITARĂ
Megakariocit trombocitogen
27 SERIA MONOCITARA Ø Formata din: • Monoblast • Promonocit • Monocit
28 MONOBLASTUL Ø Nu este identificat în MOH,
29 PROMONOCITUL 10 -20 mm ØNucleu: eucromatic, ØCitoplasma: - bazofilă, - granulaţii azurofile
30 SERIA LIMFOCITARA Ø Formata din: • Limfoblast • Limfocit tanar • Limfocit
31 LIMFOBLASTUL 10 -18 mm ØNucleu: - eucromatic - cu 1 -2 nucleoli, ØCitoplasma: - bazofilă, - cu puţine granule azurofile
32 LIMFOCITUL TANAR 9 -17 mm Ø Nucleu: cu cromatină condensată, Ø Citoplasmă: - bazofilă - în cantitate redusă, - granule azurofile
33
34
35
36